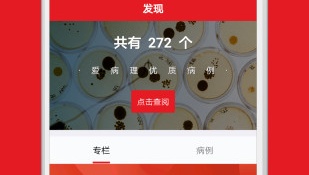
病历生成器APP

病历生成器APP
病历生成器手机app合集是小编为用户收录好用手机app汇编带来,用户可以通过本合集快速找到自己需要的手机app,而且搜索便利,下载安全快速,同时小编还会实时更新给用户带来更多好用的手机app!
-
 下载爱病理中文 65.13 MB
下载爱病理中文 65.13 MB在线咨询医生病例,与广大网友交流探讨,阅读了解健康知识
-
 下载丁香园中文 96.30 MB
下载丁香园中文 96.30 MB是一款汇集了一线医生的临床经验和病例分享
-
 下载治趣中文 42.42 MB
下载治趣中文 42.42 MB医生、医学生的临床病例学习平台
-
 下载诊疗助手中文 71.51 MB
下载诊疗助手中文 71.51 MB医生兼职、交流、学习的好平台
-
 下载掌上医讯中文 39.60 MB
下载掌上医讯中文 39.60 MB好用的医疗咨询软件,提供专业医疗咨讯。
-
 下载百姓医生患者端中文 55.28 MB
下载百姓医生患者端中文 55.28 MB医生随行,健康有保障
-
 下载链点互联网医院中文 62.43 MB
下载链点互联网医院中文 62.43 MB医生端
-
 下载医脉通中文 59.15 MB
下载医脉通中文 59.15 MB医学资讯传递,病例实战宝典
-
 下载骨今中外2024版中文 100.95 MB
下载骨今中外2024版中文 100.95 MB提供实时的帮助和咨询服务,让你更快的获得健康
-
 下载大笨象医生中文 16.70 MB
下载大笨象医生中文 16.70 MB针对口腔疾病的医疗在线软件
-
 下载图形病历本中文 15.81 MB
下载图形病历本中文 15.81 MB医疗工作者可以来更好的整理病例信息。
-
 下载牙医秀中文 64.06 MB
下载牙医秀中文 64.06 MB牙医秀—牙医的专业社交平台
-
 下载医知源中文 17.31 MB
下载医知源中文 17.31 MB专注收集各种的新权威医生认证信息
-
 下载唯医骨科中文 136.57 MB
下载唯医骨科中文 136.57 MB骨科医生的每一步都在这。
-
 下载宠医客中文 87.33 MB
下载宠医客中文 87.33 MB为兽医或者是爱宠物的用户准备的
-
 下载正雅医生中文 20.12 MB
下载正雅医生中文 20.12 MB专为医生端开发的病例提交软件。
-
 下载人卫临床助手中文 47.81 MB
下载人卫临床助手中文 47.81 MB知名专家临床病例学习中心
-
 下载临床思维综合训练系统中文 28.91 MB
下载临床思维综合训练系统中文 28.91 MB临床诊疗思维在线训练。
-
 下载医生圈中文 166.22 MB
下载医生圈中文 166.22 MB医生们的互动社区,同行学术交流平台。
-
 下载临床思维综合训练系统最新版中文 28.91 MB
下载临床思维综合训练系统最新版中文 28.91 MB临床诊疗思维在线训练。
-
 下载医艺中文 45.20 MB
下载医艺中文 45.20 MB心血管外科手术培训平台。
-
 下载宠医帮中文 99.14 MB
下载宠医帮中文 99.14 MB宠物保护平台
-
 下载放射沙龙中文 45.71 MB
下载放射沙龙中文 45.71 MB放射沙龙---你的医学影像深造学院
-
 下载唯医骨科最新版中文 136.57 MB
下载唯医骨科最新版中文 136.57 MB骨科医生工作平台
-
 下载肝胆相照中文 68.81 MB
下载肝胆相照中文 68.81 MB中国肝胆病防治专家推荐软件。
-
 下载健康之路中文 78.51 MB
下载健康之路中文 78.51 MB一款健康服务软件
-
 下载树蚁医疗中文 44.41 MB
下载树蚁医疗中文 44.41 MB了解自身健康状况
-
 下载无极云影像中文 5.53 MB
下载无极云影像中文 5.53 MB健康检查
-
 下载医护签中文 90.24 MB
下载医护签中文 90.24 MB医护人员办公必备,在线签名快捷方便,提升效率节省时间
-
 下载i厦门中文 190.93 MB
下载i厦门中文 190.93 MB统一政务服务平台
猜你喜欢





























